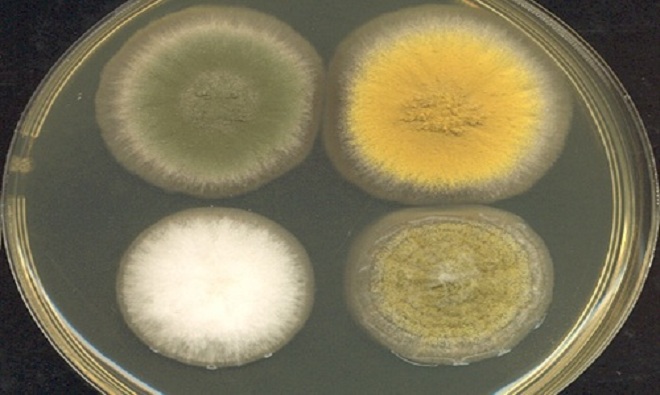
Nấm là nguyên liệu tự nhiên dùng để chế tạo thuốc, chẳng hạn penicillin. Aspergillus nidulans sẽ là loại nấm đầu tiên được mang lên trạm không gian, với mục đích phát triển loại thuốc mới dùng cả trong không gian và trên Trái Đất. Nhóm nghiên cứu dẫn đầu bởi Clay Wang, nhà dược học thuộc Đại học South California, Mỹ, đang có kế hoạch trồng các loại nấm trên không gian và mặt đất, sau đó so sánh hai nhóm về gene, protein, và chất chuyển hóa. Nhóm hy vọng môi trường không gian khiến nấm tạo ra hợp chất mới, hoặc đẩy nhanh quá trình sản xuất thuốc chữa bệnh. Ảnh: Adrian J. Hunter.

Trồng bắp cải trong vũ trụ, nuôi nấm để làm thuốc chữa bệnh, thử nghiệm nhà ở bơm phồng là những thí nghiệm có thể giúp đưa con người lên sao Hỏa do Cơ quan Hàng không vũ trụ Mỹ (NASA) tiến hành.
Trồng bắp cải trong vũ trụ, nuôi nấm để làm thuốc chữa bệnh, thử nghiệm nhà ở bơm phồng là những thí nghiệm có thể giúp đưa con người lên sao Hỏa do Cơ quan Hàng không vũ trụ Mỹ (NASA) tiến hành.
![]() |
| Theo Business Insider, các nhà du hành vũ trụ trồng thành công rau diếp trên Trạm Vũ trụ Quốc tế (ISS) kể từ tháng 5/2014. NASA đang thực hiện chương trình Veggie nhằm trồng thêm bắp cải trong không gian. |
![]() |
| Các nhà khoa học hy vọng loại bắp cải Toyko Bekana sẽ phát triển ở điều kiện môi trường không trọng lực trên ISS. Phi hành gia sẽ ăn một phần bắp cải không gian này, trong khi phần còn lại được làm lạnh, gửi về Trái Đất để tiếp tục phân tích. Trồng cây trong không gian làm thức ăn đóng vai trò rất quan trọng, giúp cung cấp các chất dinh dưỡng và duy trì sức khỏe cho phi hành gia trên đường đến sao Hỏa. Ảnh: NASA. |
![]() |
| Nấm là nguyên liệu tự nhiên dùng để chế tạo thuốc, chẳng hạn penicillin. Aspergillus nidulans sẽ là loại nấm đầu tiên được mang lên trạm không gian, với mục đích phát triển loại thuốc mới dùng cả trong không gian và trên Trái Đất. Nhóm nghiên cứu dẫn đầu bởi Clay Wang, nhà dược học thuộc Đại học South California, Mỹ, đang có kế hoạch trồng các loại nấm trên không gian và mặt đất, sau đó so sánh hai nhóm về gene, protein, và chất chuyển hóa. Nhóm hy vọng môi trường không gian khiến nấm tạo ra hợp chất mới, hoặc đẩy nhanh quá trình sản xuất thuốc chữa bệnh. Ảnh: Adrian J. Hunter. |
![]() |
| Dù chỉ có khoảng 3 - 6 phi hành gia sống trên trạm không gian, nhưng mỗi người chứa hàng triệu, hoặc hàng tỷ vi khuẩn. Kasthuri Venkateswaran, chuyên gia làm việc tại Phòng Thí nghiệm Sức đẩy Phản lực (JPL) của NASA, đang tiến hành lấy mẫu để kiểm tra sự tiến hóa của vi khuẩn theo thời gian. Phương pháp thí nghiệm là sử dụng phép phân tích ADN nhằm tìm hiểu tác động của các yếu tố môi trường không trọng lực, bức xạ, sự hiện diện của con người đến quần thể vi khuẩn. Nghiên cứu trên giúp hạn chế vi khuẩn có hại phát sinh trong các chuyến bay dài ngày của con người ngoài vũ trụ. Những vi khuẩn có lợi trong không gian khác với trên Trái Đất sẽ được khai thác để phục vụ lợi ích của con người, Venkateswaran cho biết. Ảnh: NASA. |
![]() |
| Do lực hấp dẫn trên Trạm Vũ trụ Quốc tế yếu hơn so với Trái Đất nên các phi hành gia mất rất nhiều khối lượng cơ bắp trong chuyến bay vũ trụ dài ngày. Công ty phát triển dược phẩm Eli Lilly sẽ thử nghiệm một loại kháng thể mới, giúp ngăn ngừa suy giảm bắp thịt ở 20 con chuột. Nếu thử nghiệm thành công, nó không chỉ giúp ích cho các nhà du hành vũ trụ mà còn cho nhiều người trên Trái Đất mắc bệnh xơ cứng teo cơ (ALS), teo bắp thịt liên quan đến độ tuổi. Ảnh: NASA. |
![]() |
| Phản ứng chuỗi trùng hợp (PCR) là kỹ thuật phổ biến trong lĩnh vực sinh học phân tử, nhằm tạo ra nhiều bản sao của một đoạn ADN mà không cần sử dụng sinh vật sống như E.coli hay nấm men. Các nhà khoa học dự định tiến hành thí nghiệm để xem PCR có làm việc trong không gian hay không, qua đó tìm ra phương pháp phát hiện những thay đổi di truyền mà phi hành gia gặp phải khi thực hiện chuyến bay vũ trụ dài ngày. Ảnh: NASA. |
![]() |
| NASA dự kiến thử nghiệm nhà ở bơm phồng, hay Module Hoạt động Mở rộng Bigelow (BEAM), kết nối với ISS vào cuối tháng 5 hoặc đầu tháng 6. Dù module BEAM chỉ có kích thước bằng một phòng ngủ nhỏ, nhưng công nghệ này ảnh hưởng rất lớn đến tương lai thăm dò không gian của con người. Các cảm biến sẽ đánh giá tác động của những mảnh vỡ, cũng như mức độ phóng xạ và nhiệt độ bên trong module BEAM. Phi hành gia đi vào và rời khỏi module khoảng 4 - 6 lần mỗi năm, với thời gian 3 giờ mỗi lần. Trong lần đi vào đầu tiên, các phi hành gia có thể dạo chơi trong module mà không cần bộ đồ du hành vũ trụ hay thiết bị hỗ trợ sự sống nào khác. Module BEAM sẽ mở đường cho các trạm không gian tư nhân trên quỹ đạo Trái Đất, cũng như nhà ở bơm hơi gọn nhẹ gửi tới Mặt Trăng hoặc sao Hỏa. Ảnh: Bigelow Aerospace. |
Theo VnExpress